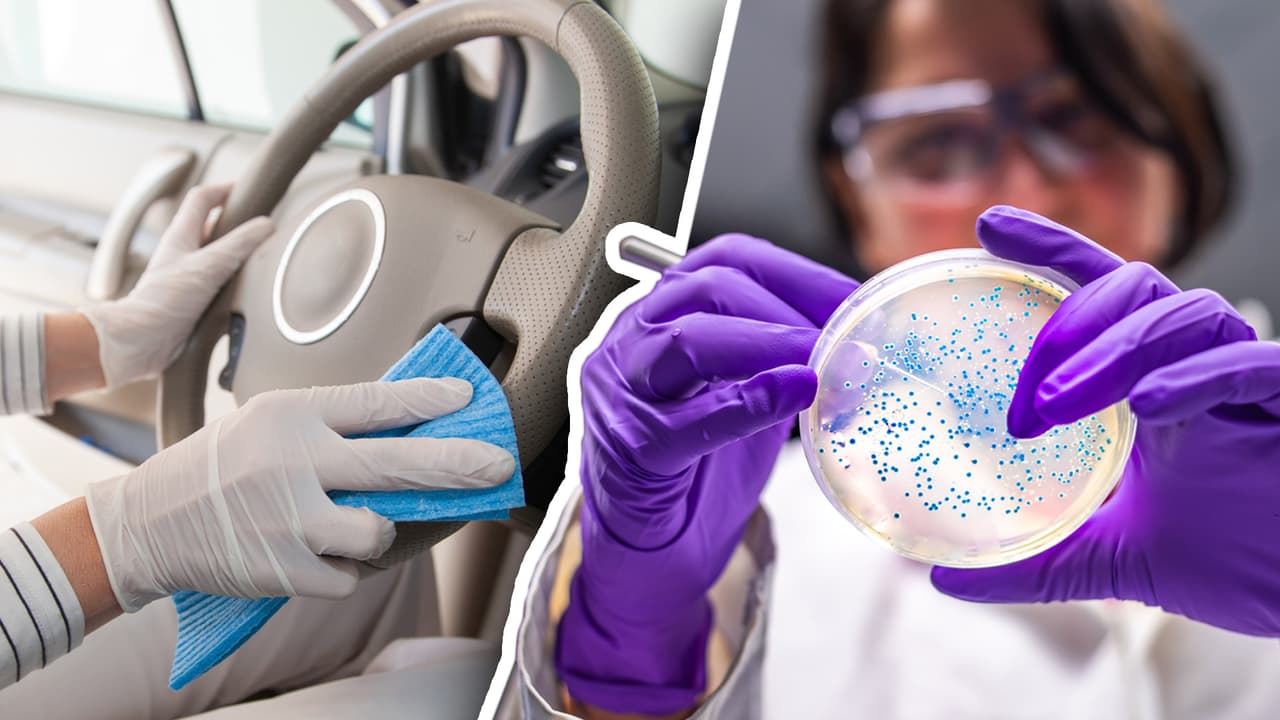

Científicos de los CDC anuncian que el COVID-19 no se propaga tan fácilmente en las superficies
Los Centros para el Control y Prevención de Enfermedades reevaluaron los tiempos y la posibilidad de la permanencia del virus en determinadas superficies, como el aluminio, y decidieron revelar esta información para aliviar el estrés de las personas que temen contagiarse. Descarga gratis Uforia App.

Por:Univision
Publicado el 22 may 20 - 08:47 PM EDT.